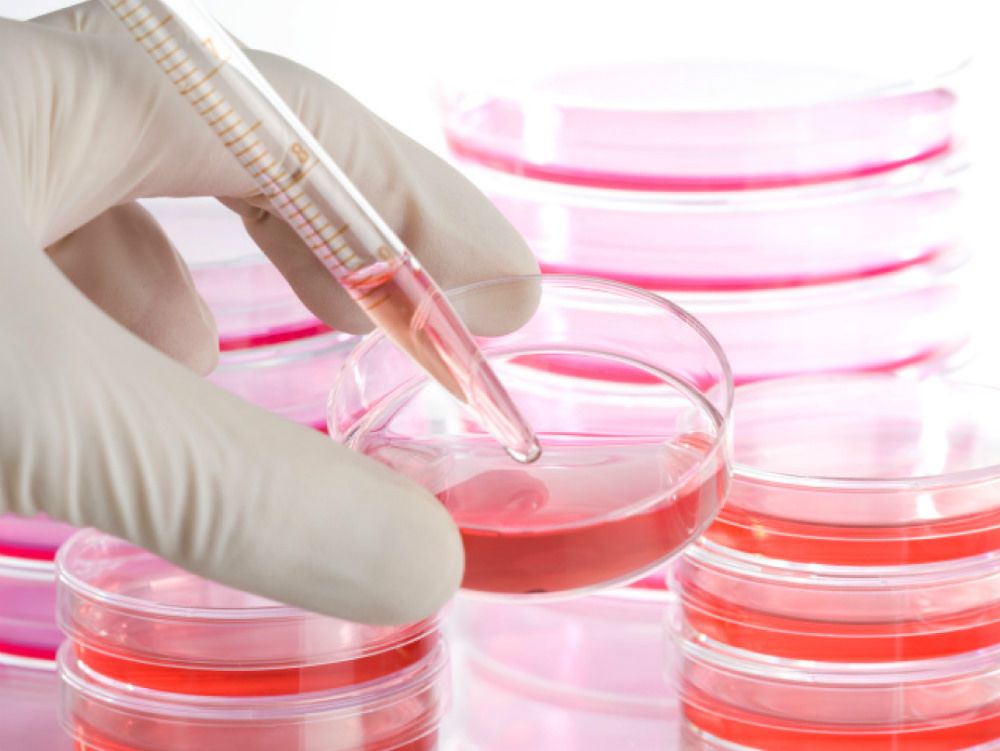
Metodo Stamina, muore bimba calabrese

Metodo Stamina, muore bimba calabrese
Non hanno intenzione di rinunciare i genitori dei bambini malati gravi che vogliono effettuare le infusioni con il metodo Stamina, che domattina saranno a Brescia sotto la sede degli Ospedali civili…
Non hanno intenzione di rinunciare i genitori dei bambini malati gravi che vogliono effettuare le infusioni con il metodo Stamina, che domattina saranno a Brescia sotto la sede degli Ospedali civili, nonostante gli inviti diramati nei giorni scorsi dall`ospedale a non presentarsi, perché i trattamenti non riprenderanno il 5 maggio. Assieme a loro ci sarà Davide Vannoni, presidente della Stamina Foundation, che alla vigilia di un raduno nato in maniera quasi spontanea sui social network assicura che “non ci saranno problemi di ordine pubblico”. La vigilia di questo appuntamento a Brescia è stata intanto funestata dalla morte di una bimba calabrese, Gaia, affetta da Sma1, in lista per accedere alle infusioni. “Faccio appello al ministro Lorenzin perché ordini subito la ripresa della sperimentazione convocando il Comitato scientifico – ha dichiarato il segretario nazionale di Io Cambio, Agostino D`Antuoni che ha detto che domani sarà a Brescia con Vannoni – il ministro ci aiuti a garantire la ripresa delle cure”. Il ministro della Salute, Beatrice Lorenzin, ha detto venerdì scorso che al riguardo attende “il responso del secondo comitato, dopodiche` potremo mettere parola fine a questa vicenda”. “Comprendo benissimo la situazione delle famiglie – ha aggiunto il ministro riferendosi ai pazienti che chiedono di proseguire le cure – ho parlato con tanti di loro. Ma l`Italia è un Paese del primo mondo, non del terzo, dobbiamo garantire le cure a tutti, ma se si rispecchiano ad una evidenza e ai minimi di protocolli di sperimentazione. Ad oggi tutto quello che noi sappiamo di questo metodo – ha concluso – è assolutamente negativo, c`è anche un processo in corso. Ma comunque, siccome non sono uno scienziato né un ricercatore, attendo il responso del comitato”.